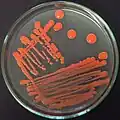
Rhodotorula mucilaginosa (klassen Microbotryomycetes); en encellet gærsvamp, der lever i mange økosystemer, og her ses danne kolonier på medium i en Petriskål.

Basidiesvampe
Basidiesvampe (Basidiomycota) er en række inden for svamperiget, der er kendetegnet ved at sporerne sidder fire sammen for enden af et såkaldt basidie. Basidiesvampe udgør en af to rækker i svampenes underrige Dikarya, den anden er sæksvampe (Ascomycota). Basidiesvampe indeholder tre underrækker: Agaricomycotina, Pucciniomycotina og Ustilaginomycotina.
| Basidiomycota |
| |||||||||||||||||||||||||||||||||||||||
Kladogram, der viser basidiesvampenes inddeling i underækker og klasser.[2][3]
| Basidiesvampe | |
|---|---|
 Almindelig kantarel (Gloioxanthomyces vitellinus) | |
| Videnskabelig klassifikation | |
| Domæne | Eukaryota (Eukaryoter) |
| Rige | Fungi (Svampe) |
| Underrige | Dikarya |
| Række |
Basidiomycota R.T.Moore (1980)[1] |
| Underrækker | |
| |
| Hjælp til læsning af taksobokse | |

Agaricomycotina
Agaricomycotina indeholder omkring 20.000 arter, og omkring 98% af disse er i klassen Agaricomycetes, som inkluderer de fleste svampe der er kendt som paddehatte, herunder flere populære spiselige svampe som champignoner og kantareller.[4] Arter i Agaricomycotina, der ikke er Agaricomycetes, omfatter gelesvampe, visse "gær", øresvampe og andre; disse er samlet som Klasserne Tremellomycetes og Dacrymycetes der bl.a. omfatter bævresvampe og visse typer af "gær"svampe, der kan være sygdomsfremkaldende, fx Cryptococcus (klassen Tremellomycetes). Wallemiomycetes er en tidlig søstergruppe til resten af Agaricomycotina.[5]
 Broget skørhat (Russula cyanoxantha) (klassen Agaricomycetes); lamelsvamp der danner mykorrhiza med bøg.[6]
Broget skørhat (Russula cyanoxantha) (klassen Agaricomycetes); lamelsvamp der danner mykorrhiza med bøg.[6]_op_dode_tak_van_een_eik_15-01-2021._(actm.)_02.jpg.webp) Gul bævresvamp (Tremella mesenterica) (klassen Dacrymycestes); snylter på Ege-voksskind (en anden svamp)[7]
Gul bævresvamp (Tremella mesenterica) (klassen Dacrymycestes); snylter på Ege-voksskind (en anden svamp)[7] Cryptococcus neoformans (klassen Tremellomycetes); en encellet svamp, der inficerer lunger på patienter med svækket immunforsvar
Cryptococcus neoformans (klassen Tremellomycetes); en encellet svamp, der inficerer lunger på patienter med svækket immunforsvar Wallemia sebi (klassen Wallemiomycetes) er en encellet gærsvamp, der her danner kolonier på fast medium i en Petriskål.
Wallemia sebi (klassen Wallemiomycetes) er en encellet gærsvamp, der her danner kolonier på fast medium i en Petriskål.
Pucciniomycotina
Pucciniomycotina findes i mange forskellige økologiske nicher og kan leve som parasitter på insekter og svampe, og som orkidémykorrhiza, de er også blevet påvist i jord og vand. De fleste er plantepatogener og kan gøre stor økonomisk skade i jordbruget. Mange Pucciniomycotina er rustsvampe og er placerede i rækken Puccinales (klassen Pucciniomycetes), der indeholder cirka 7800 arter (ca. 90% af gruppen).[8]
Rhodotorula mucilaginosa (klassen Microbotryomycetes); en encellet gærsvamp, der lever i mange økosystemer, og her ses danne kolonier på medium i en Petriskål.
Rhodotorula mucilaginosa (klassen Microbotryomycetes); en encellet gærsvamp, der lever i mange økosystemer, og her ses danne kolonier på medium i en Petriskål. Skvalderkål-tvecellerust (Puccinia aegopodii) (klassen Pucciniomycetes) er en parasit på skvalderkål.[9]
Skvalderkål-tvecellerust (Puccinia aegopodii) (klassen Pucciniomycetes) er en parasit på skvalderkål.[9] Cyphobasidium sp. (klassen Cystobasidiomycetes) parasiterer på Skæglav (Usnea sp.) (billedet).[10] Lav er en symbiose mellem en svamp (hyppigst en sæksvamp) og en grønalge.
Cyphobasidium sp. (klassen Cystobasidiomycetes) parasiterer på Skæglav (Usnea sp.) (billedet).[10] Lav er en symbiose mellem en svamp (hyppigst en sæksvamp) og en grønalge.
Ustilaginomycotina
Ustilaginomycotina omfatter 115 slægter med mere end 1700 arter.[4] De er for det meste parasitter på karplanter. De har stor negativ økonomisk betydning i jordbruget.
_5187022.png.webp)
 Tyttebær angrebet af Exobasidium vaccinii (klassen Exobasidiomycetes)
Tyttebær angrebet af Exobasidium vaccinii (klassen Exobasidiomycetes)
Referencer
- Moore, R.T. (1980). "Taxonomic proposals for the classification of marine yeasts and other yeast-like fungi including the smuts". Botanica Marina. 23: 371.
- James TY, Stajich JE, Hittinger CT, Rokas A (2020) Toward a Fully Resolved Fungal Tree of Life. Arkiveret 5. oktober 2021 hos Wayback Machine Annual Review of Microbiology 74: 291-313. doi: 10.1146/annurev-micro-022020-051835.
- Li Y, Steenwyk JL, Chang Y, Wang Y, James TY, Stajich JE, Spatafora JW, Groenewald M, Dunn CW, Hittinger CT, Shen XX, Rokas A (2021) A genome-scale phylogeny of the kingdom Fungi. Current Biology 31: 1653-1665 doi: 10.1016/j.cub.2021.01.074.
- Hibbett, D.S. et al. (2007) A higher-level phylogenetic classification of the Fungi. Mycological Research 111: 509-47. doi: 10.1016/j.mycres.2007.03.004.
- Padamsee, M.; Kumar, T. K.; Riley, R.; Binder, M.; Boyd, A.; Calvo, A. M.; Furukawa, K.; Hesse, C.; Hohmann, S.; James, T. Y.; LaButti, K.; Lapidus, A.; Lindquist, E.; Lucas, S.; Miller, K.; Shantappa, S.; Grigoriev, I. V.; Hibbett, D. S.; McLaughlin, D. J.; Spatafora, J. W.; Aime, M. C. (marts 2012). "The genome of the xerotolerant mold Wallemia sebi reveals adaptations to osmotic stress and suggests cryptic sexual reproduction". Fungal Genetics and Biology. 49 (3): 217-26. doi:10.1016/j.fgb.2012.01.007. PMID 22326418.
- Broget skørhat. Danmarks Svampeatlas.
- Gul bævresvamp; Danmarks Svampeatlas.
- Aime MC, Matheny PB, Henk DA, Frieders EM, Nilsson RH, Piepenbring M, McLaughlin DJ, Szabo LJ, Begerow D, Sampaio JP, Bauer R, Weiss M, Oberwinkler F, Hibbett D (2006) An overview of the higher level classification of Pucciniomycotina based on combined analyses of nuclear large and small subunit rDNA sequences. Mycologia 98: 896-905. doi: 10.3852/mycologia.98.6.896.
- Skvalderkål-tvecellerust. Danmarks Svampeatlas.
- Millanes AM, Diederich P, Wedin M (2016) Cyphobasidium gen. nov., a new lichen-inhabiting lineage in the Cystobasidiomycetes (Pucciniomycotina, Basidiomycota, Fungi). Fungal Biology 120: 1468-1477. doi: 10.1016/j.funbio.2015.12.003.
Eksterne henvisninger
- Jens H. Petersen: Svamperiget, 1998 ISBN 87-12-03330-8
- December 2004: Systema Naturae 2000: Phylum Basidiomycota Arkiveret 29. december 2004 hos Wayback Machine
- Svampeguiden: Matsvampe
 |
Wikimedia Commons har medier relateret til: |